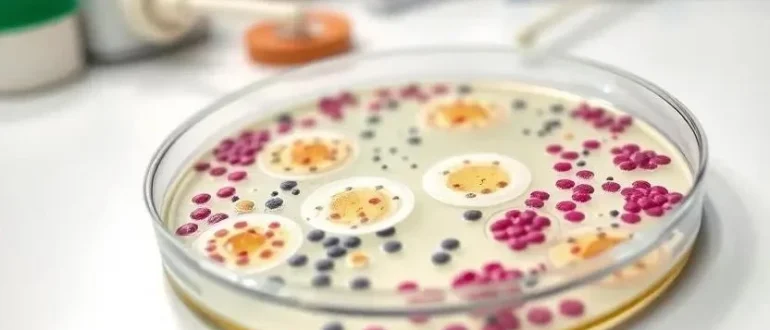

Болезни растений
Узнайте, когда бактериальная инфекция требует хирургического вмешательства! Разбираем причины, методы лечения и протоколы, чтобы вы были в курсе.
Усиливаем действие антибиотиков! Физиотерапия – мощный помощник при бактериальных инфекциях. Узнайте, как быстрее вернуться к здоровью и победить воспаление.
Устали от антибиотиков, которые больше не работают? Фаготерапия – это инновационный метод лечения бактериальных инфекций с помощью бактериофагов. Узнайте больше!
Постоянные болезни ребенка? Узнайте, как отличить бактериальную инфекцию от простуды, какие симптомы требуют немедленного обращения к врачу и как предотвратить осложнения. Советы для родителей!
В России растет число бактериальных инфекций! Узнайте о коклюше, кори, пневмонии и кишечных инфекциях, их влиянии на здоровье и экономику страны. Будьте в курсе!
Узнайте о новейших антибиотиках, их работе и способах борьбы с устойчивостью бактерий! Защитите себя и близких от опасных инфекций. Подробный обзор.
Беспокоит здоровье? Узнайте о распространенных бактериальных инфекциях у мужчин, их скрытых симптомах, точной диагностике и эффективных методах лечения. Сохраните мужское здоровье!
Устали от дискомфорта? Разбираемся в причинах бактериальных инфекций у женщин, как распознать симптомы и эффективно избавиться от проблемы. Здоровье – это просто!
Ребенок часто болеет? Узнайте, как отличить бактериальную инфекцию от обычной простуды, какие симптомы требуют внимания и когда пора к врачу. Полезные советы и анализы!
Листья в пятнах, стебель гниет? Не паникуйте! Узнайте, как распознать и вылечить бактериальные инфекции растений, чтобы ваши зеленые питомцы снова были здоровы и красивы.